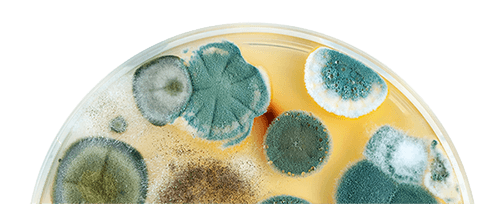
Mold in a bowl

CALL: (503) 433-2486
Probiotic Mold Removal
The Healthy & Affordable Alternative to Conventional Mold Remediation
(503) 433-2486Free Quote
We Use Probiotics
Probiotics are the most effective way of killing mold
Our Probiotics are the Most Effective Remedy against Mold!
(503) 433-2486Free Quote




